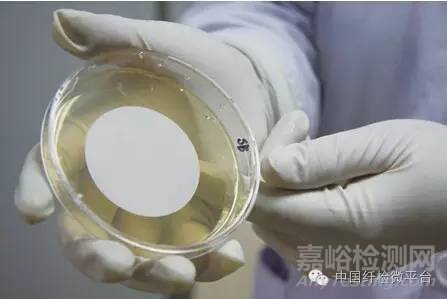
羽絨服檢測(cè)項(xiàng)目

您當(dāng)前的位置:檢測(cè)資訊 > 法規(guī)標(biāo)準(zhǔn)
嘉峪檢測(cè)網(wǎng) 2016-11-03 16:51
一件羽絨服是否合格,要經(jīng)過(guò)物理、化學(xué)等一系列項(xiàng)目的檢測(cè)進(jìn)行判定。而羽絨服與其它紡織服裝的不同在于填充物是羽絨,因此羽絨是否合格就相當(dāng)重要。
羽絨檢測(cè)項(xiàng)目知多少?
羽絨是否合格一般要經(jīng)過(guò)9個(gè)項(xiàng)目的檢測(cè)來(lái)判定。按照羽絨服產(chǎn)品標(biāo)準(zhǔn)要求,經(jīng)過(guò)檢測(cè)并達(dá)到有關(guān)指標(biāo)要求的產(chǎn)品,才是可以放心穿著的產(chǎn)品。
羽絨主要檢測(cè)項(xiàng)目
1充絨量
在對(duì)羽絨服進(jìn)行恒溫恒濕處理后,對(duì)羽絨服整體稱重再進(jìn)行拆卸,使羽絨填充物和服裝面料分離。因?yàn)橛鸾q體積小且極輕,易四處飛散,容易損失,所以不能直接稱取羽絨重量得出羽絨服充絨量,而是應(yīng)該用羽絨服總重量減去面料重量,算出充絨量。
2耗氧量
耗氧量:在100g試樣中,消耗氧的毫克數(shù)。 按標(biāo)準(zhǔn)制取3mol/L的硫酸溶液、0.02mol/L的高錳酸鉀溶液。同清潔度方法制備樣液。用移液管吸取100mL樣液(蒸餾水100ml做空白試驗(yàn))置于三角燒杯中,加入3mol/L硫酸2mL。用微量滴定管滴入0.02mol/L的高錳酸鉀溶液至終點(diǎn),分別記錄高錳酸鉀消耗的毫升數(shù),經(jīng)過(guò)計(jì)算得出耗氧量。 耗氧量高低與微生物指標(biāo)超標(biāo)與否密切相關(guān)。
按照標(biāo)準(zhǔn)規(guī)定的方法制取樣液,在光線不低于600lx處,把搖勻的樣液倒入透明度計(jì)內(nèi),靜置一分鐘,觀察桶底的雙十字線,如看不清楚,則從下部緩緩放出樣液,直至看清楚底部的雙十字線,記錄統(tǒng)內(nèi)壁凹液面的底部在筒壁的刻度位置,刻度值即為清潔度。
蓬松度指羽毛羽絨的彈性程度。按照標(biāo)準(zhǔn)規(guī)定稱取經(jīng)過(guò)前處理的羽絨28.5g,逐把抖入蓬松度儀內(nèi),用玻璃棒充分?jǐn)嚢璨伷?。放入鋁質(zhì)壓板,1分鐘后記錄蓬松儀桶兩壁刻度值,取其平均值。重復(fù)實(shí)驗(yàn)三遍,得蓬松度測(cè)定值。蓬松度高的衣服,相對(duì)保暖效果比較好。
含絨量指絨子和絨絲在羽絨羽毛中的含量百分比。在羽絨檢測(cè)實(shí)驗(yàn)中,含絨量、絨子含量檢測(cè)最為耗時(shí)。檢測(cè)人員需把4g樣品中的絨子、絨絲、毛片、羽絲和雜質(zhì)等分別揀出,計(jì)算絨子和絨絲占試樣含量的百分比即得含絨量。而含絨量檢測(cè)也是羽絨羽毛檢測(cè)中最重要的一項(xiàng)實(shí)驗(yàn),因?yàn)楹q量反應(yīng)羽絨品質(zhì)的高低、保暖效果的好壞以及經(jīng)濟(jì)價(jià)值。
嗜溫性需氧菌:在36℃±2℃的溫度下,在氧中發(fā)育的微生物,主要是細(xì)菌的含量。 通過(guò)培養(yǎng)箱培養(yǎng)菌落總數(shù),用來(lái)判定羽絨制品被細(xì)菌污染的程度及衛(wèi)生質(zhì)量,它反映羽絨制品在生產(chǎn)過(guò)程中是否符合衛(wèi)生要求。嗜溫性需氧菌會(huì)引發(fā)人體呼吸道、腸道疾病以及皮膚過(guò)敏、瘙癢等癥狀,危害消費(fèi)者身體健康。
糞鏈球菌多來(lái)源于動(dòng)物的糞便,如果該指標(biāo)不合格,可引起人類心內(nèi)膜炎、腦膜炎、化膿性腹部感染、敗血癥、腹瀉、發(fā)燒、尿路感染等多種疾病。
亞硫酸還原梭狀芽孢桿菌在自然界中可以存活時(shí)間很久,即使在經(jīng)過(guò)適當(dāng)加工處理的羽絨中仍會(huì)存活,因此通常被作為長(zhǎng)期污染或間斷污染的指標(biāo)菌。該菌是羽毛羽絨檢測(cè)中主要微生物指標(biāo)之一,也是引起產(chǎn)品不合格的主要污染菌。
在自然界中,沙門氏菌廣泛寄生在雞、鴨、鵝等家禽的腸腔內(nèi),如果患病動(dòng)物屠宰后用于加工服裝更易傳播病菌。因此,沙門氏菌也是羽絨制品在做生物指標(biāo)中的必檢項(xiàng)目。


3羽絨清潔度

4蓬松度

5含絨量

6嗜溫性需氧菌

7糞鏈球菌


8亞硫酸還原梭狀芽孢桿菌

9亞硫酸還原梭狀芽孢桿菌

來(lái)源:中國(guó)纖檢微平臺(tái)